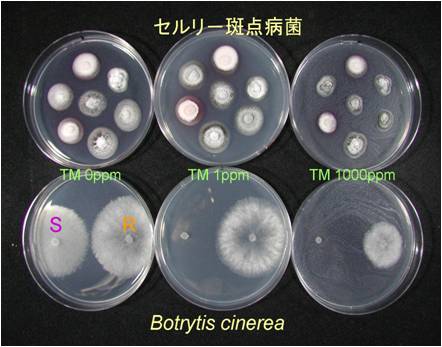

セルリーの斑点病(耐性菌の発生)
斑点病はセルリーの最も重要な病害であり、多発すると減収することから、薬剤散布による防除が行われている。平成18〜19年に中央農試場内で薬剤試験を行ったところ、チオファネートメチル水和剤の散布区で全く効果が認められず、耐性菌の発生が疑われた。そこで、道内のセルリー主産地である洞爺湖町で平成18年4〜6月に合計7筆、大空町で平成19年9月に3筆のハウスから斑点病罹病葉を採取し病原菌を分離した。得られた合計176菌株についてチオファネートメチル水和剤に対する感受性検定を行ったところ、全ての菌株がPDA培地への本剤添加濃度2000μg/mlでも生育し、高度耐性を示した。チオファネートメチル水和剤は本病に古くから登録があり、平成16〜17年度の洞爺湖町での実態調査では、いずれの作型でも栽培中に1〜2回使用されているケースが多く、長年に渡り道内で使用されてきた。しかし、前述の通り本剤の斑点病に対する防除効果が皆無であることからも、本病に対してはチオファネートメチル水和剤の使用は避ける必要があると考えられた。
(中央農試)